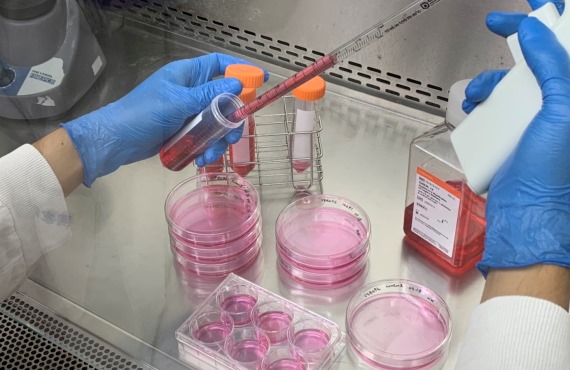
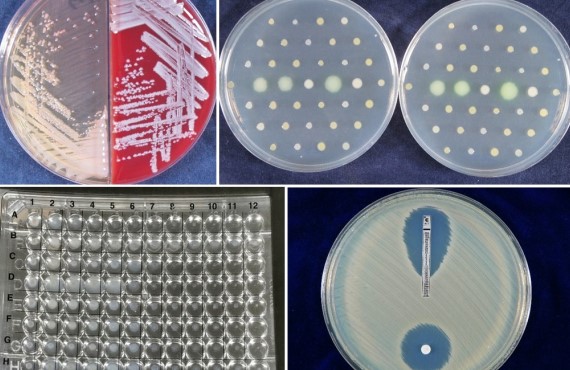

病毒


病毒培養與分離是病毒學研究中的重要技術與基礎,透過病毒培養獲得足夠的研究材料,能夠幫助研究人員瞭解病毒的生物學特性及病毒與宿主細胞之間的交互作用,並找出可能的預防與治療方法。然而,病毒培養存在著許多困難。由於病毒為絕對寄生的微生物,本身缺乏自主繁殖與生存的能力,必須依賴宿主細胞才能進行複製和增殖。研究人員需選用適合的細胞株、雞胚蛋或是動物,進行接種,並提供適當的營養與環境,確保細胞及病毒的生長和繁殖。最後從培養液或細胞中收取病毒,並進行鑒定和純化。整個過程皆需仰賴實驗室人員熟練的技術和豐富的經驗,也需要嚴格控制實驗室環境,避免交叉污染,影響材料品質以及防止病毒外洩,造成人員危害。 NIDB病毒資源庫有多種病毒培養的經驗,並提供各式重要人類病毒株分讓服務,以及病毒代培養服務,可滿足學術界及生技產業界研究所需。
病毒鑑定是一個重要的技術,通常用於醫學中,協助疾病的診斷與治療。傳統多仰賴免疫學(ELISA,IFA,Western Blot)、電子顯微鏡或PCR等技術,近期更發展出快篩試劑、RT-qPCR或基因體學的方法。透過這些技術,實驗室人員可以確定病原體的種類、數量和活性,以及它們在樣本中的分佈。NIDB病毒資源庫透過各種免疫學及分子生物學等方法,檢測所生產的病毒,以確保提供給各產學單位的生物材料的正確性。
仿真病毒泛指利用不同種類的病毒外殼蛋白與基因體製成的重組病毒,透過結合慢病毒包裹系統,可以生產出攜帶各式蛋白但卻無法再進行複製的重組慢病毒,使研究人員得以在常規生物安全等級第二級(BSL-2) 的實驗室操作。其應用範圍十分廣泛,包含研究病毒與宿主細胞受體的親和性、疫苗開發及抗體確效等。由於仿真病毒能有效降低研究風險,NIDB病毒資源庫也提供以慢病毒載體系統所製備之高效價仿真病毒作為研究媒介。
NIDB細菌資源庫團隊長期蒐集國內重要抗藥性菌株資料,熟悉細菌培養、菌種鑑定、抗藥性分析等技術,並透過微生物學、分子生物學、基因體等實驗進行後續加值分析。
真菌資源庫長期蒐集國內重要酵母菌及絲狀真菌菌株,熟悉真菌培養、菌種分子鑑定、臨床及環境檢體真菌檢測、CLSI標準抗真菌藥物敏感性試驗、小分子/化合物抗真菌效率測試、抗藥機轉分析、菌株親緣關係分析、斑馬魚疾病與毒性檢測模式等技術。
奈米孔定序是一種由英國Oxford Nanopore Technologies(ONT)所開發的第三代 DNA 定序技術。其原理是將DNA片段通過微細的奈米孔道,並即時監測 DNA 分子通過時所引起的電流變化,進而解析DNA的鹼基序列。相較於傳統定序方法,ONT奈米孔定序具有多項顯著優勢:能提供更長的讀長(long-read),具備即時數據生成的特性,可在現場快速取得結果,且不受特定序列或GC含量限制。此外,它在高通量、速度與精確度上均具競爭力,特別適合應用於病原體全基因體定序、結構變異偵測與複雜基因區域的解析。這項技術的彈性與擴充性,讓研究人員能以更低的成本與更短的時間獲取關鍵基因體資訊,進一步推動臨床診斷、疫情監測與公共衛生研究。
使用免疫缺陷小鼠建立特定感染病原動物模式,用此動物模式評估特定藥物或益生菌對不同感染性疾病的發生或症狀是否具抑制或改善功效。 實績: 1.抗真菌藥物臨床前測試:分析藥物或生物製劑抑制腸胃道念珠菌感染及對不同抗藥性念珠菌的影響 2.益生菌降低腸胃道病原感染測試:分析益生菌抑制腸胃道念珠菌或困難梭孢菌感染的效果